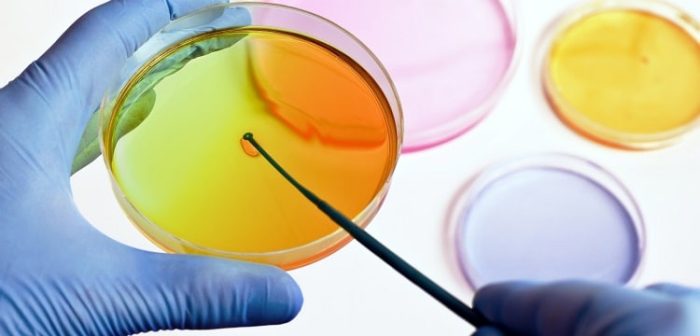
placa de petri microbiología

Historia Destacada

Resumen Ejecutivo
Descubra los materiales de laboratorio que se utilizan en los laboratorios de microbiología, desde placas de Petri y microscopios hasta incubadoras y láminas autosellantes. Aprenda cómo se utilizan para recoger y analizar datos con precisión en esta entrada del blog de COTECNO.
Historia Completa
Descubra los materiales de laboratorio que se utilizan en los laboratorios de microbiología, desde placas de Petri y microscopios hasta incubadoras y láminas autosellantes. Aprenda cómo se utilizan para recoger y analizar datos con precisión en esta entrada del blog de COTECNO.
Los materiales de laboratorio son esenciales para la microbiología. Desde placas de Petri e incubadoras hasta microscopios y criostatos, el equipo adecuado es vital para recoger y analizar con precisión los datos en el laboratorio. En esta entrada del blog, hablaremos de los materiales más comunes utilizados en un laboratorio de microbiología y de sus usos.
Los 5 Materiales de Laboratorio Esenciales que Necesitas en un Laboratorio de Microbiología
-
Placas de Petri
-
Incubadoras
Las incubadoras son un equipo esencial en cualquier laboratorio de microbiología, ya que proporcionan un entorno óptimo para el crecimiento de cultivos durante largos periodos de tiempo. Las incubadoras tienen distintos tamaños y capacidades, según el espacio que necesites para cultivar tus muestras. La temperatura del interior de una incubadora debe controlarse cuidadosamente para garantizar que se mantiene dentro de un determinado intervalo adecuado para el crecimiento de los cultivos.
-
Microscopios
El microscopio es una de las herramientas más importantes de cualquier laboratorio de microbiología, ya que permite a los investigadores ver los organismos a nivel microscópico. Hay microscopios de muchas formas y tamaños, desde modelos sencillos para estudiantes hasta modelos avanzados para investigación con funciones especializadas, como capacidad de imagen digital y movimientos automatizados de la platina. Independientemente del tipo de microscopio que tengas, siempre debe manejarse con cuidado debido a su naturaleza delicada.
-
Película Auto – Sellante Termoplástica

Te puedes Interesar: ¿Qué es una película auto – sellante y cuáles son sus principales aplicaciones?
-
Criostatos
Los criostatos son otra pieza importante del equipo de laboratorio utilizado en los laboratorios de microbiología. Estos aparatos permiten a los científicos congelar rápidamente muestras biológicas para poder almacenarlas a temperaturas muy bajas (-80 °C) sin que se deterioren con el tiempo. Esto los hace ideales para almacenar especímenes frágiles, como bacterias o muestras de tejidos, que deben permanecer intactos durante su almacenamiento o transporte a largo plazo. Los criostatos también permiten a los científicos controlar con precisión la temperatura durante los experimentos que implican procesos de congelación o enfriamiento.
Conclusión
Como puedes ver, hoy en día hay una gran variedad de materiales de laboratorio disponibles para su uso en los laboratorios de microbiología -desde placas de Petri e incubadoras hasta microscopios y criostatos-, cada uno con su propia finalidad y función cuando se realizan investigaciones o experimentos con microorganismos o muestras biológicas. Todos estos materiales desempeñan un papel importante a la hora de ayudar a los científicos a recopilar datos precisos que puedan analizarse más adelante. Con estos conocimientos, puedes asegurarte de que tu laboratorio dispone de todo el equipo necesario
Conoce un poco más sobre Congreso Chileno de Microbiología
Conversemos
¿Necesitas apoyo para implementar esta solución? Nuestro equipo técnico puede ayudarte.
Agendar con Cotecno